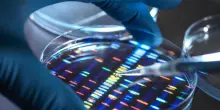

s

Per diventare cittadini francesi si dovrà superare un test di gastronomia
18-10-2025, 17:23
Anche i principali piatti della cucina transalpina nel nuovo esame per chi richiede la cittadinanza
CONTINUA A LEGGERE

13

0

0
Guarda anche
Il Resto del Carlino

La maturità si passa ai fornelli: tutti promossi
Libero Quotidiano

Immigrazione, mossa della Lega: "Esame per diventare italiani"
HuffPost
Ieri, 21:09
Notte fonda a Bruxelles sugli asset russi. Spunta il piano B: debito comune
HuffPost
Ieri, 19:23
Regolari ma clandestini. Gli esodati del decreto flussi di Meloni
HuffPost
Ieri, 18:35
Spionaggio russo in Europa. Cnn: "007 di Mosca imbarcati su petroliere ombra"
HuffPost
Ieri, 18:09
Gli agricoltori appiccano incendi, l'Ue mette in ghiaccio il Mercosur
HuffPost
Ieri, 16:45